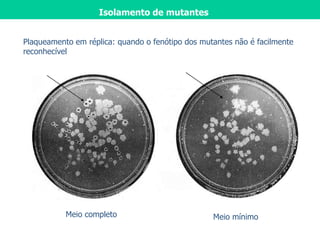
Isolamento de mutantes
Meio completo Meio mínimo
Plaqueamento em réplica: quando o fenótipo dos mutantes não é facilmente
reconhecível :

1) O documento discute a expressão gênica e regulação gênica em procariotos, com foco no operon lac de E. coli.
2) O operon lac é composto de três genes que codificam enzimas para processar a lactose. Um desses genes codifica a enzima beta-galactosidase.
3) A expressão do operon lac é regulada pela presença ou ausência de glicose e lactose no meio, por meio de proteínas repressoras e ativadoras.